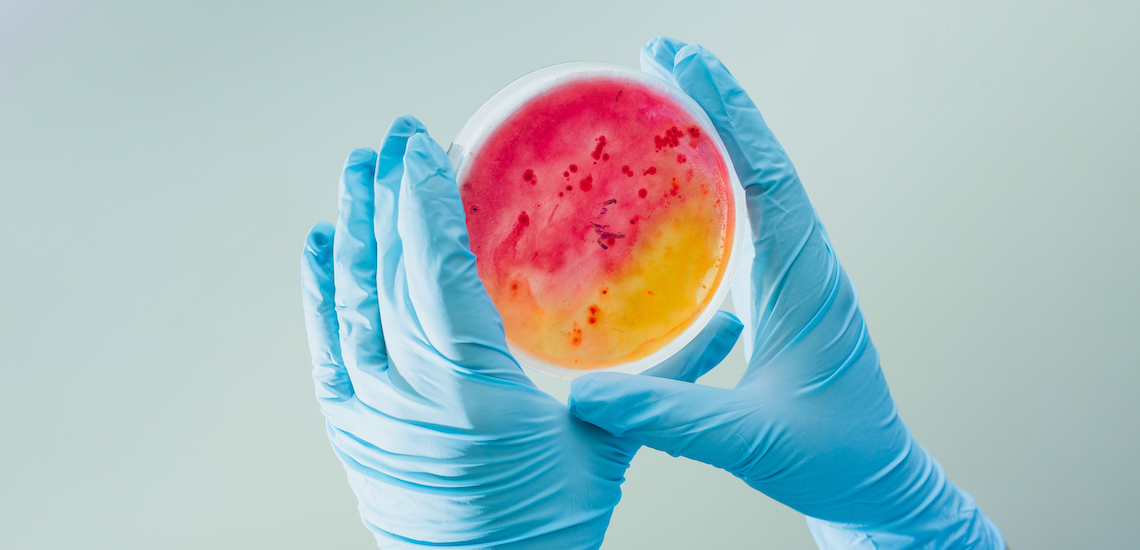
Bigstock--165932648

Introduction
The direct objective of the Synthesis+ excellence program is to develop and expand the synthetic capacity of ELTE TTK. The indirect goal of the program is to strengthen, coordinate and enhance the synergies between colleagues, workshops and communities related to synthetic works, so that we can be more effective in research, more effective in development, focus on some areas of innovation.
In the coming years, therefore, we are planning to
- strengthen, link and network different synthetic and associated disciplines,
- introduce the practice of competing cooperation,
- catalyze specialty synergy, and
- promote the collaboration between already successful researchers and their workshops and materially support them.
Events
Recent
More Recent EventsNews
Synthesis+ workshop 2022-05-18
19 May 2022, Thursday 14.00
Location: ELKH TTK 1117 Budapest, Magyar Tudósok körútja 2. Small room
Synthesis+ workshop 2022-04-11
21 April 2022, Thursday 14.00
Location: ELKH TTK 1117 Budapest, Magyar Tudósok körútja 2. Small room
Synthesis+ workshop via Microsoft Teams 2022-03-08
17. March 2022, Thursday 14.00
Amino acid analyser 2022-02-25
We present a new microanalytical instrument, an amino acid analyser, from the Institute of Chemistry, ELTE TTK. The new instrument reliably serves the needs of research, industrial projects and university education.
400 MHz NMR 2022-02-14
We present the latest member of the family of the ELTE Institute of Chemistry, the 400 MHz NMR instrument, which is highly automated. With its state-of-the-art technology, it quickly and efficiently serves not only BSc and MSc education, but also routine research needs.